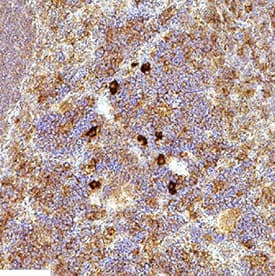

Mouse TIM-3 Antibody
R&D Systems, part of Bio-Techne | Catalog # AF1529


Key Product Details
Validated by
Species Reactivity
Validated:
Cited:
Applications
Validated:
Cited:
Label
Antibody Source
Product Specifications
Immunogen
Leu22-Arg191
Accession # AAL65156
Specificity
Clonality
Host
Isotype
Scientific Data Images for Mouse TIM-3 Antibody
Detection of Mouse TIM‑3 by Western Blot.
Western blot shows lysates of RAW 264.7 mouse monocyte/macrophage cell line. PVDF membrane was probed with 2 µg/mL of Goat Anti-Mouse TIM-3 Antigen Affinity-purified Polyclonal Antibody (Catalog # AF1529) followed by HRP-conjugated Anti-Goat IgG Secondary Antibody (Catalog # HAF017). A specific band was detected for TIM-3 at approximately 45-70 kDa (as indicated). This experiment was conducted under reducing conditions and using Immunoblot Buffer Group 1.TIM-3 in Mouse Spleen.
TIM-3 was detected in immersion fixed paraffin-embedded sections of mouse spleen using Goat Anti-Mouse TIM-3 Antigen Affinity-purified Polyclonal Antibody (Catalog # AF1529) at 3 µg/mL for 1 hour at room temperature followed by incubation with the Anti-Goat IgG VisUCyte™ HRP Polymer Antibody (VC004). Before incubation with the primary antibody, tissue was subjected to heat-induced epitope retrieval using Antigen Retrieval Reagent-Basic (CTS013). Tissue was stained using DAB (brown) and counterstained with hematoxylin (blue). Specific staining was localized to lymphocytes. Staining was performed using our protocol for IHC Staining with VisUCyte HRP Polymer Detection Reagents.Detection of Mouse TIM-3 by Immunohistochemistry
Blocking TIM-3 significantly reduces brain injury after hypoxia-ischaemia.(a) Representative images of TTC-stained brain slices from H/I mice treated with 100 μg of IgG (n=12) or anti-TIM-3 antibody (n=12). The infarct volume was quantified with Image J analyser and expressed as a percentage of the damaged ipsilateral hemisphere. (b) Representative magnetic resonance images (MRIs) from TIM-3-antibody-treated mice (n=4) and IgG-treated mice (n=4) at 24 h post-H/I. (c) Representative T2 images from TIM-3-antibody-treated mice (n=4) and IgG-treated mice (n=4) after H/I. (d) The extent of the oedema formation was obtained from the T2-weighted MRI images and ADC map. (e) Representative confocal microscopic images of immunohistochemical staining for NeuN and cleaved caspase-3 in coronal brain sections from IgG- and anti-TIM-3-treated H/I mice 24 h after injury. Scale bar, 50 μm. The graph shows the mean number of NeuN and cleaved caspase-3-stained cells per mm2. (f) Immunoblot detection of full-length PARP proteins in contralateral and ipsilateral cortex regions of control IgG- or anti-TIM-3-treated mice. The graph shows the relative levels of full-length PARP (116 kDa). Data represent the mean±s.d. from at least three independent experiments. Image collected and cropped by CiteAb from the following publication (https://pubmed.ncbi.nlm.nih.gov/25790768), licensed under a CC-BY license. Not internally tested by R&D Systems.Applications for Mouse TIM-3 Antibody
CyTOF-ready
Flow Cytometry
Sample: HT-2 mouse T cell line
Immunohistochemistry
Sample: Immersion fixed paraffin-embedded sections of mouse spleen
Western Blot
Sample: RAW 264.7 mouse monocyte/macrophage cell line
Formulation, Preparation, and Storage
Purification
Reconstitution
Formulation
Shipping
Stability & Storage
- 12 months from date of receipt, -20 to -70 °C as supplied.
- 1 month, 2 to 8 °C under sterile conditions after reconstitution.
- 6 months, -20 to -70 °C under sterile conditions after reconstitution.
Background: TIM-3
TIM-3 (T cell immunoglobulin and mucin domain-3) is a 60 kDa member of the TIM family of immune regulating molecules. TIMs are type I transmembrane glycoproteins with one Ig-like V-type domain and a Ser/Thr-rich mucin stalk (1-3). There are three TIM genes in human and eight in mouse. Mature mouse TIM-3 consists of a 174 amino acid (aa) extracellular domain (ECD), a 21 aa transmembrane segment (TM), and a 67 aa cytoplasmic tail (4). Two alternately spliced isoforms have been reported in mouse which lack either the TM or both the TM and mucin regions (5, 6). Within the ECD, mouse TIM-3 shares 58% and 74% aa sequence identity with human and rat TIM-3, respectively. TIM-3 is specifically expressed on Th1 cells whereas TIM-1 and TIM-2 are expressed on Th2 cells. In chronic inflammation, autoimmune disorders, and some cancers, TIM-3 is upregulated on several other hematopoietic cell types and on hippocampal neurons (9-12). The glycosylated Ig domain of TIM-3 binds cell-associated galectin-9 which induces TIM-3 Tyr phosphorylation and proapoptotic signaling (10, 13). TIM-3 functions as a negative regulator of Th1 cell activity. Its blockade results in increased IFN-gamma production, Th1 cell proliferation, and cytotoxicity (5, 7, 12, 14). TIM-3 may play a role in regulatory T cell development (7), inflammation (15), and immune tolerance (5, 13, 14). Soluble mouse TIM-3 has been shown to inhibit anti-tumor effector T cell responses and to enhance autoimmune reactions (6, 7).
References
- Anderson, A.C. and D.E. Anderson (2006) Curr. Opin. Immunol. 18:665.
- Mariat, C. et al. (2005) Phil. Trans. R. Soc. B 360:1681.
- Meyers, J.H. et al. (2005) Trends Mol. Med. 11:362.
- Monney, L. et al. (2002) Nature 415:536.
- Sabatos, C.A. et al. (2003) Nat. Immunol. 4:1102.
- Geng, H. et al. (2006) J. Immunol. 176:1411.
- Sanchez-Fueyo, A. et al. (2003) Nat. Immunol. 4:1093.
- Khademi, M. et al. (2004) J. Immunol. 172:7169.
- Wiener, Z. et al. (2007) J. Invest. Dermatol. 127:906.
- van de Weyer, P.S. et al. (2006) Biochem. Biophys. Res. Commun. 351:571.
- Gielen, A.W. et al. (2005) J. Neuroimmunol. 164:93.
- Oikawa, T. et al. (2006) J. Immunol. 177:4281.
- Zhu, C. et al. (2005) Nat. Immunol. 6:1245.
- Koguchi, K. et al. (2006) J. Exp. Med. 203:1413.
- Frisancho-Kiss, S. et al. (2006) J. Immunol. 176:6411.
Long Name
Alternate Names
Entrez Gene IDs
Gene Symbol
UniProt
Additional TIM-3 Products
Product Documents for Mouse TIM-3 Antibody
Product Specific Notices for Mouse TIM-3 Antibody
For research use only